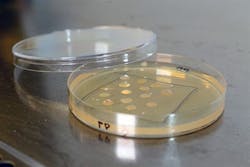
vtt-plastbug vtt-plastbug

Container Coverts Plastic Waste Into Chemicals, Fuel
By Alyssa Edmunds
In VTT’s PlastBug projects, microbes are being screened through a three-stage process. (Photo: VTT)
Earlier this summer I mentioned in my blog post, Businesses And Meatless Mondays Tackle Greenhouse Gases, that I had been trying to cut back my plastic consumption. Saving the environment is very important to me, so I did not let the fact that I moved back to school impede my efforts. I bought all reusable dishes and a reusable K-cup for my Keurig. Often, I feel like my efforts to protect the environment are meaningless; one individual’s plastic-free lifestyle is ineffective in the grand scheme of things. That’s why it excites me so much when I see scientists working to effect change at a larger scale, like the scientists at VTT Technical Research Centre of Finland Ltd.VTT is working to develop a mobile container unit called the PlastBug that will degrade plastic waste in the ocean and turn it into fuel or chemicals. The container would get most of the energy it needs from renewable energy sources, like solar or wind energy. Currently, researchers are looking for microbes that are able to degrade different types of plastic. The developers of this projects still have much work to do, but their goal is to use the PlastBug in the Baltic Sea by 2021. If all goes well, they can be commercially produced and used in various locations throughout the world in just a few years.
Alyssa Edmunds is Chemical Processing’s social media intern and a student at The Ohio State University. She is studying Actuarial Science. She is also lowering her carbon footprint one cup of coffee at a time.